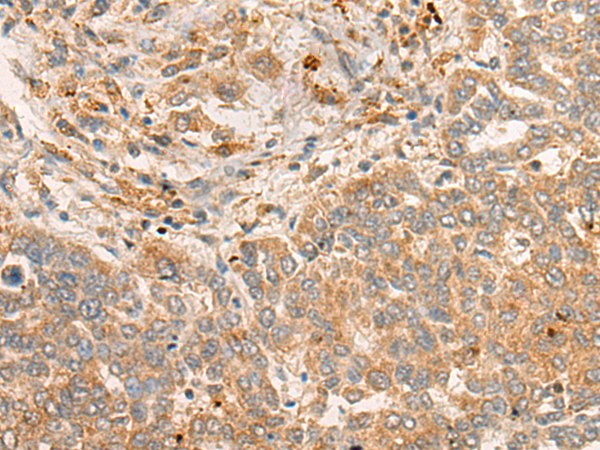

|
Background: |
This gene encodes a member of the F-box protein family which is characterized by an approximately 40 amino acid motif, the F-box. The F-box proteins constitute one of the four subunits of the ubiquitin protein ligase complex called SCFs (SKP1-cullin-F-box), which function in phosphorylation-dependent ubiquitination. The F-box proteins are divided into 3 classes: Fbws containing WD-40 domains, Fbls containing leucine-rich repeats, and Fbxs containing either different protein-protein interaction modules or no recognizable motifs. The protein encoded by this gene belongs to the Fbxs class and contains an F-box domain. This protein is highly expressed during muscle atrophy, whereas mice deficient in this gene were found to be resistant to atrophy. This protein is thus a potential drug target for the treatment of muscle atrophy. Alternative splicing results in multiple transcript variants encoding different isoforms. |
|
Applications: |
ELISA, IHC |
|
Name of antibody: |
FBXO32 |
|
Immunogen: |
Synthetic peptide corresponding to a region derived from 69-82 amino acids of human FBXO32 |
|
Full name: |
F-box protein 32 |
|
Synonyms: |
Fbx32; MAFbx |
|
SwissProt: |
Q969P5 |
|
ELISA Recommended dilution: |
5000-10000 |
|
IHC Positive control: |
Human liver cancer;Human prostate cancer |
|
IHC Recommended dilution: |
30-150 |

購物車
購物車 幫助
幫助
 021-54845833/15800441009
021-54845833/15800441009
